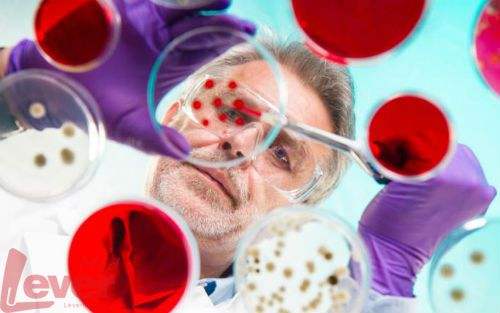
基因

基因测试可能不会改变人们不健康的方式
预测人们患疾病风险的基因测试变得越来越普遍,但是一项新的分析表明,掌握这些信息并不意味着人们会采取行动。

英国研究人员审查了18项研究的结果,这些研究着眼于癌症和心脏病等疾病的通讯DNA检测结果是否能促使人们做出健康的改变。
他们没有发现任何证据表明人们采取健康的行为,如戒烟或吃得更健康,接受他们的DNA结果。
评论作者指出,个人既没有动机做出健康的改变,也没有气馁。
Theresa Marteau博士说,审查的研究没有解决为什么测试结果未能促进减少风险的行为。她说,最有可能的原因是“风险认知充其量只对行为有小影响”。分析3月15日发表在BMJ。
Isaac Lipkus,在Durham,N.C.的杜克大学护理学院的一名教授,他研究的风险沟通,说医学文献显示“弱,如果有的话,提供行为改变遗传信息的影响。”
但是Mary Freivogel,在丹佛的一个癌症遗传咨询,想知道DNA结果在剑桥交付给患者分析。
对于那些没有接受遗传咨询,就像“给人一种在没有任何指示几百件组装的工具,”Freivogel说,国家遗传顾问协会的总统。
今天,基因组测序的进展——绘制个人DNA密码和检测基因变异信号的能力——使得人们至少可以在理论上识别其遗传疾病风险。
按2012的UnitedHealth集团的报告显示,美国遗传与分子测试在2010年为500万美元上涨,到2021年价格升到150亿美元和250亿美元左右。

这项研究的作者说,十多年来,欧洲和加拿大的几家公司已经将一系列常见的、复杂的疾病直接卖给消费者。
他说:“在美国,我们报告航母的状态、特征和血统,而不是疾病风险。”
作者从10000多篇研究摘要中提取了18项研究报告。其中包括一些遗传风险的研究,这些因素可能会随着生活方式的改变而改变,如戒烟、饮食改变或体力活动。
剑桥研究小组排除了诸如亨廷顿氏病等遗传性疾病的研究,没有减少风险的已知干预措施。
总的来说,有什么建议给人们的遗传风险信息,使他们能够改变他们的生活方式,尤其是吃得更健康,Marteau说。
同时,研究人员补充说,从他们的遗传信息中,没有任何负面影响,如抑郁和焦虑。
作者建议在解释结果时要谨慎,列举了一些局限性,包括许多研究的质量较差。
然而,DNA检测仍然有助于临床医生识别和治疗处于危险中的人。
“对于公众来说,我们的信息是“买者自负”——买家当心,”Marteau说。
她补充说:“基因测试可能会发现医疗干预可以降低风险的风险,但这将是个人明智地与初级保健医师讨论的问题。”